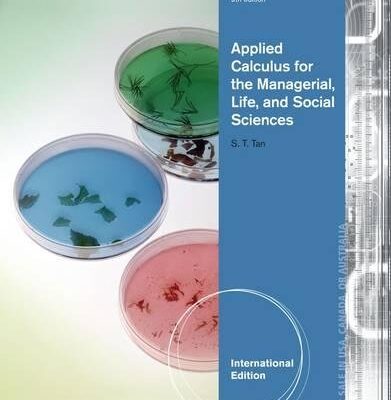
APPLIED CALCULUS FOR THE MANAGERIAL, LIFE, AND SOCIAL SCIENCES 9TH EDITION

Description
- ISBN-10: 1133960197
- ISBN-13: 978-1133960195
- Edition: 9th edition
- Publisher: Brooks/Cole
- Publication date: 1 January 2013
- Language: English
- Dimensions: 21.6 x 2.7 x 27.6 cm
- Print length: 896 pages
Original price was: ₹6,230.00.₹5,607.00Current price is: ₹5,607.00.
Unlock the power of calculus with Soo Tan’s APPLIED CALCULUS FOR THE MANAGERIAL, LIFE, AND SOCIAL SCIENCES, 9th Edition, available at The Bookish Owl. This essential textbook masterfully blends real-world applications, effective teaching strategies, and modern technology, making calculus accessible and engaging for students across managerial, life, and social science disciplines. Whether you’re a major or non-major, Tan’s intuitive approach demystifies abstract concepts through relatable examples and insightful case studies. Deepen your understanding with numerous exercises and integrated algebra reviews, ensuring a strong foundation for academic success. Explore how professionals in diverse fields utilize calculus in their daily work through compelling ‘Portfolios’.
5 in stock